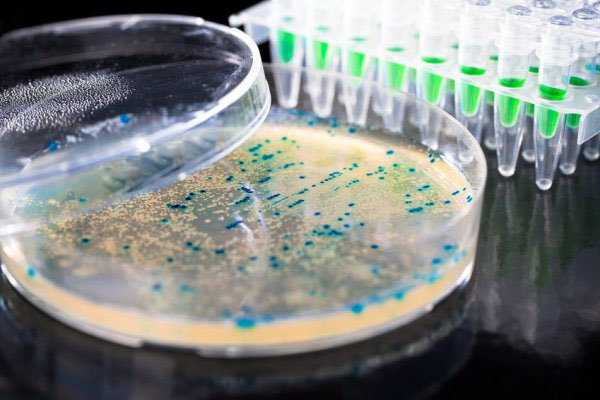

新研究发现人体微菌产生数千种未知蛋白质
斯坦福大学一份新研究发现人体内微生物可产生4000多种以前人们都不知道的蛋白种类。这些蛋白很小,每个只有不到50个氨基酸的长度,科学家认为它们对人体健康和新抗生素开发具有重要意义。

人体肠道内的微菌环境示意图。
人体内就像一个复杂的世界,里面生活着数万亿细菌。大量证据显示,人体的健康与这些细菌的种类组成、防线的坚固性有着密不可分的联系。科学家还不清楚它们之间具体究竟如何运作。
斯坦福大学医学院的研究者发现人体内这些微生物,竟然产生着数千种很小的、以前科学家从来没注意过的蛋白。他们认为,这些蛋白质对不同菌株之间竞争在生物系统内的优先权、细菌之间、它们和宿主之间的通信,以及维护细菌日常健康和最佳状态,起着重要作用。
这些蛋白每个都不到50个氨基酸的长度。这份研究的主要作者Ami Bhatt认为,它们很可能以其独特的形状构成科学家以前所不知道的基础物质,并且有很多功能,包括充当微菌的“生物开关”,帮助微菌在不同功能态切换,以及激发对其它细胞的特定反应等。
为了找到这些微小蛋白,研究者放大了细菌基因组。

“细菌基因组就像一本写有长串字母的书,只有某一部分蕴藏着制造蛋白需要的信息。”Bhatt说,“通常,我们在书中寻找夹在‘起始’和‘结束’记号之间的基因码。这种方法对于较大的蛋白适用,对于较小的蛋白,得到的结果有很多不确定的因素。”
通过对比多次重复出现的结果进行确认,研究者竟然发现了4,539种小型蛋白。“老实说,我们不知道会找到多少种,”Bhatt说,“我们对此没有任何预期。找到了几千种新蛋白,这让我们很惊讶。”
现在研究者们正进一步查明这些蛋白的作用,比如通过了解蛋白在微菌竞争肠道空间中所起的作用、如何抗药的机制,就可以发明相应的新抗生素针对相关的蛋白。
“它们比大个的蛋白更容易研究和合成得到,可促进药物开发。我们估计这将是生物学里一个相当有价值的研究领域。”Bhatt说。
这份研究近期发表在《细胞》(Cell)期刊上。

发表你的评论吧返回顶部
!评论内容需包含中文
